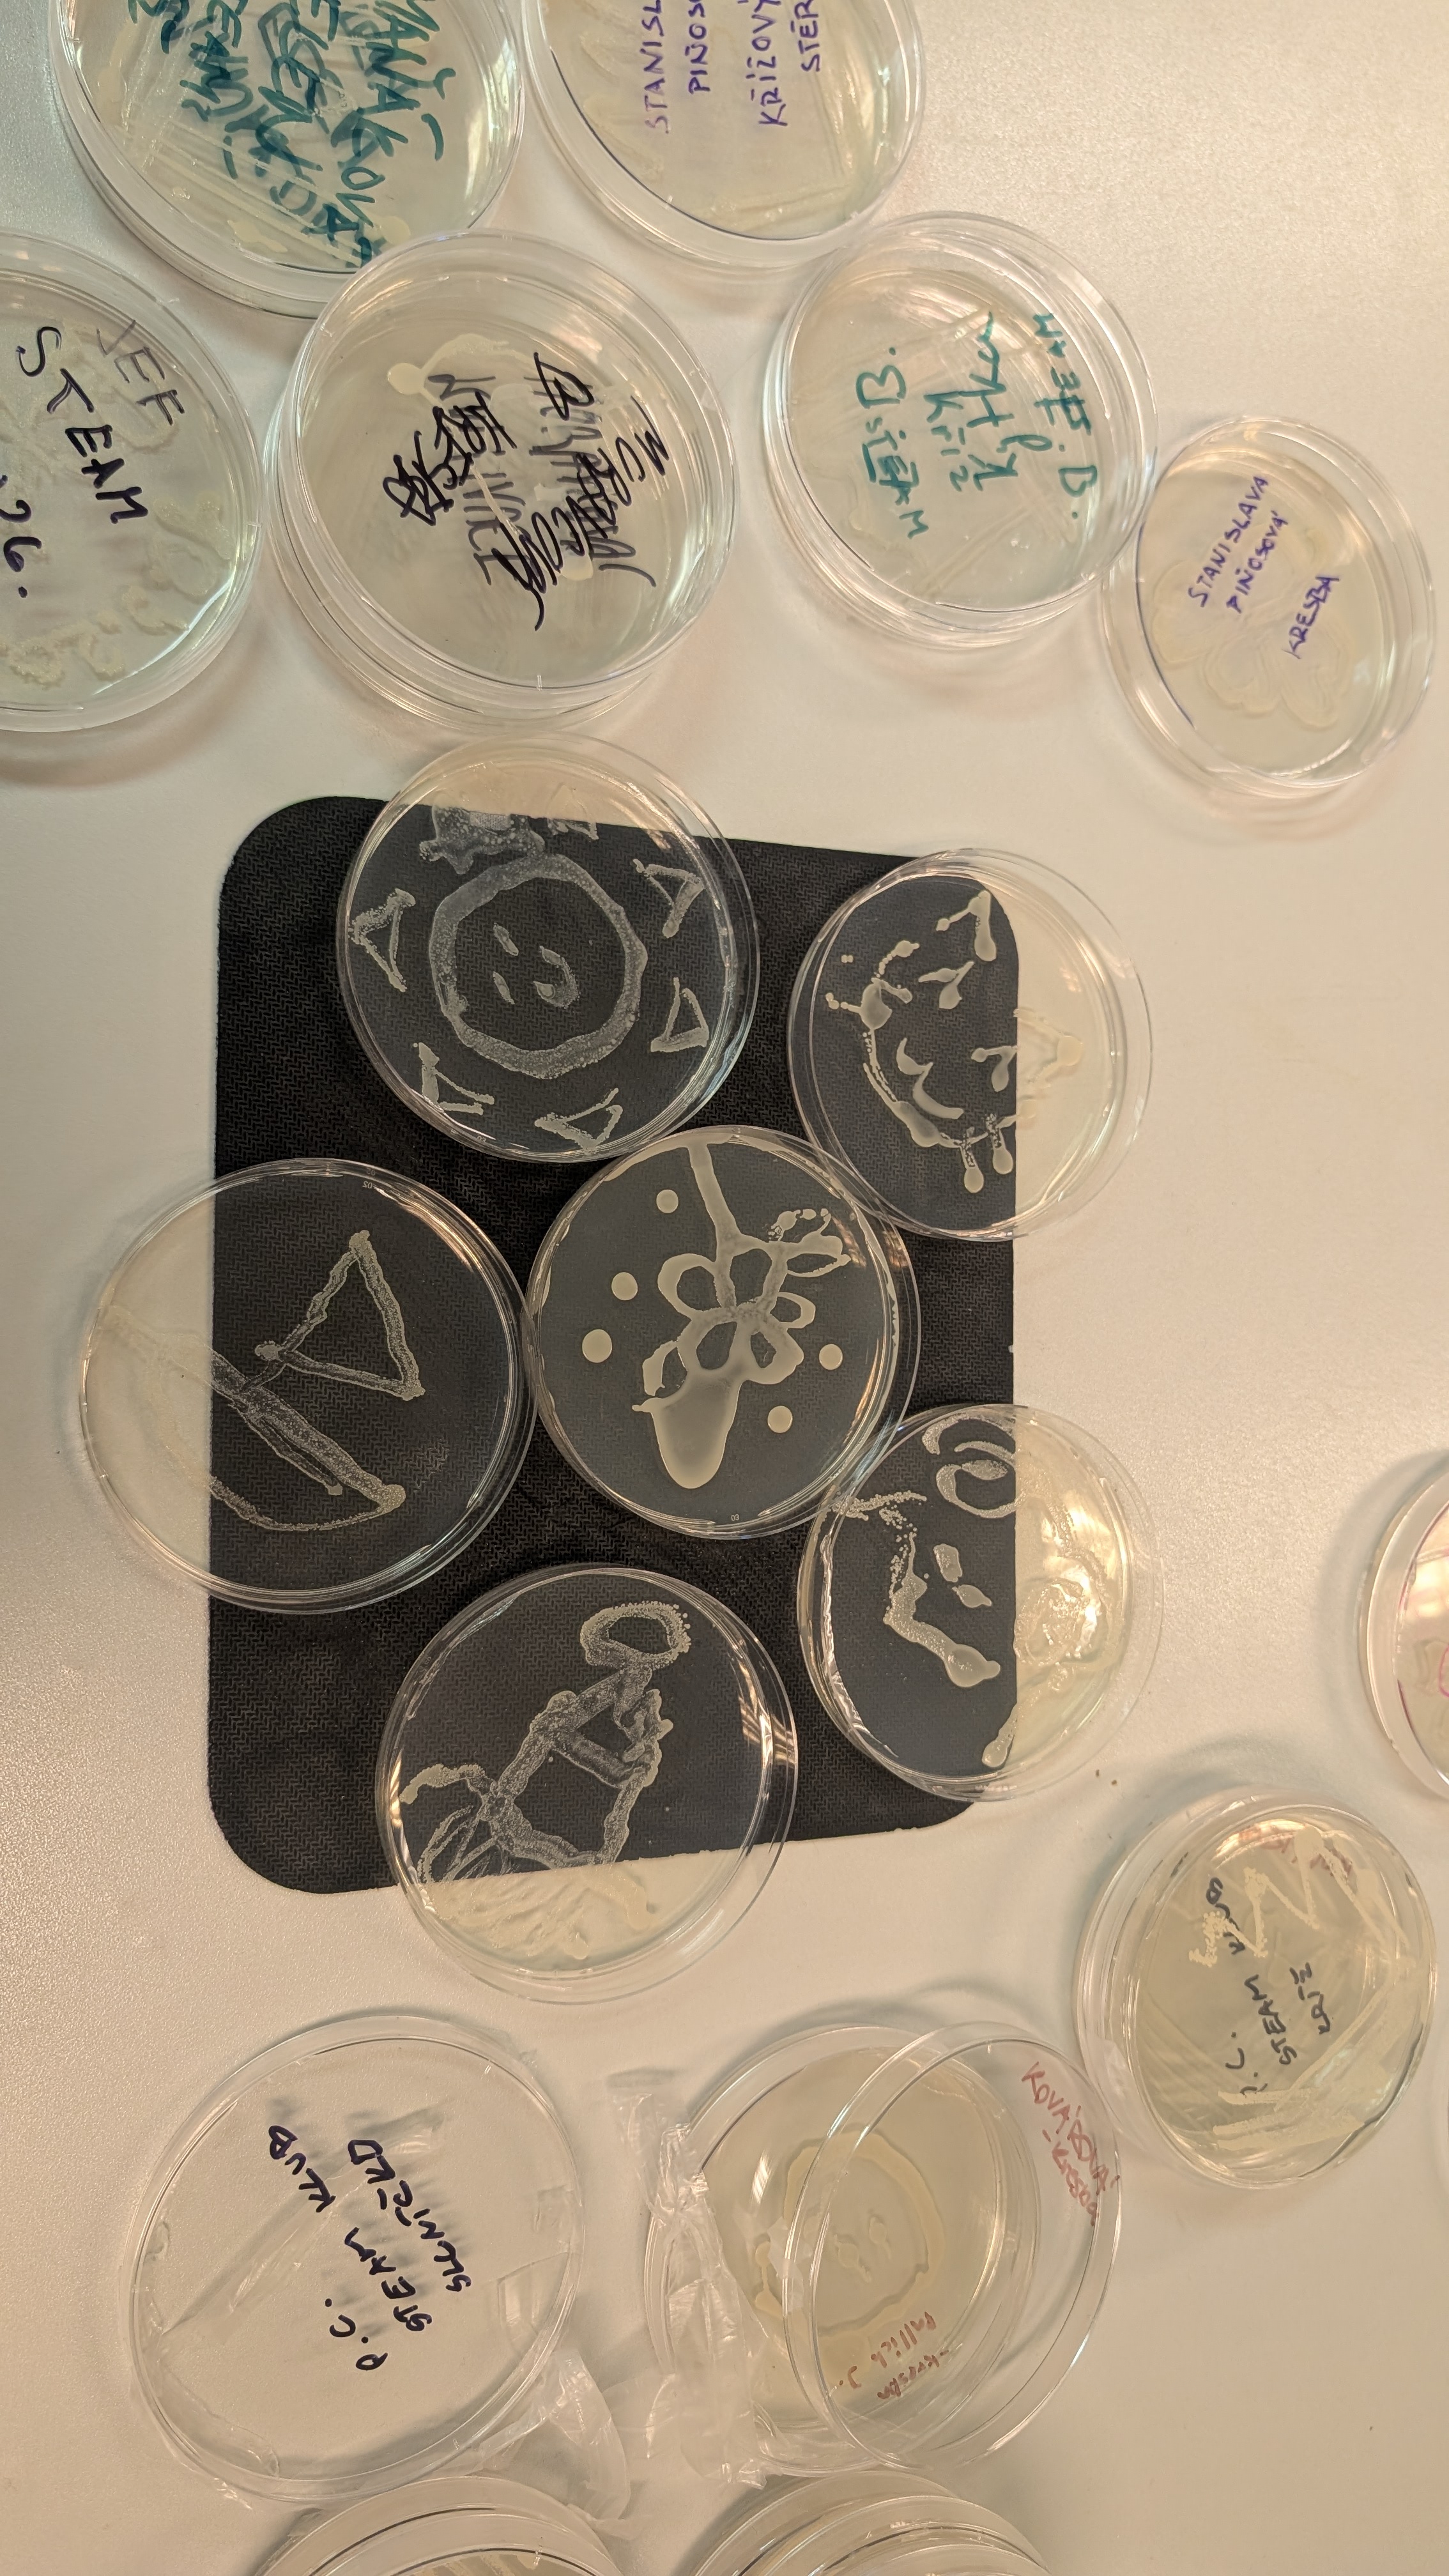

Přijď si s námi užít AHA momenty z našich pokusů s bakteriemi a bioplasty na STEAM Slam 2026!
„Mohla jsem si vyzkoušet laborky, které ve škole bohužel nemám.“
„Účast mně pomáhá s rozhodnutím, kam na vysokou školu.“
21. a 28. 4. 2026 Ekodesign: země zemi
Recyklace materiálu: vyrábíme nové ze starého.
Biodegradační test: sledujeme rozklad bioplastu v půdě.

31.3., 7. 4. a 14. 4. 2026 Z Biopolymeru Bioplast: tvoříme, testujeme vlastnosti video
Představte si to jako vaření luxusního guláše – do základu přidáváme "koření" ve formě:
Barviv: Aby materiál vypadal skvěle.
Plniv: Pro úpravu objemu a ceny.
Aditiv: Která ladí pevnost, pružnost nebo rázovou houževnatost.
Jakmile máme namíchaný ideální recept, přichází na řadu výroba tiskové struny (filamentu). Z upraveného bioplastu vytvoříme přesné vlákno, které slouží jako palivo pro naše 3D tiskárny.
Výroba ale končit nesmí. Inženýr si musí být jistý, že jeho materiál v praxi neselže. Proto se věnujeme mechanickému testování, kde bioplasty nešetříme.
„Není plast jako plast. Zatímco jeden se pod tlakem ohne, druhý praskne jako sklo.“


17. a 24. 3. 2026 Když mikrobi pracují naplno video
Sledujeme růst bakteriálních kultur v reálném čase a hlídáme klíčové fáze jejich vývoje.
Ukončujeme kultivaci přesně ve chvíli, kdy mikroorganismy začínají tvořit a ukládat cenný biopolymer PHA.
Sklízíme narostlé buňky a pomocí odstřeďování je oddělujeme od kultivačního média.
Připravujeme získanou biomasu k dalšímu zpracování a následné analýze obsahu polymeru.

10. 3. 2026 Když biopolymer vzniká uvnitř buňky
Zkoumáme mikroorganismy, které mají unikátní schopnost přirozeně produkovat polyhydroxyalkanoáty (PHA).
Připravujeme specifická kultivační média, která zajistí bakteriím ideální podmínky pro růst a tvorbu biopolymeru.
Osvojujeme si profesionální aseptické techniky, abychom udrželi naše laboratorní prostředí v naprosté čistotě.
Zakládáme první kultivace, čímž spouštíme klíčový úvodní krok celé biotechnologické výroby bioplastu.



